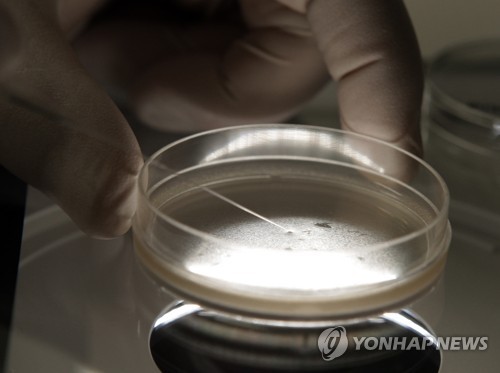
▲ 세포 관련 이미지 ⓒ연합뉴스

-
- ▲ 세포 관련 이미지 ⓒ연합뉴스
동종유래 세포치료제의 관리 체계가 부실하다는 의혹이 일면서 관련 업체들에 대한 재평가도 불가피할 전망이다.
18일 업계에 따르면 지난 15일 식품의약품안전처(이하 식약처)는 세포치료제 개발 업체인 코오롱생명과학, 테고사이언스, 메디포스트, 바이오솔루션 등 4개 업체에 대한 실사를 시행했다.
식약처는 긴급 실사의 사유를 밝히지 않았으나 업계에서는 세포치료제 관리 실태를 확인하기 위한 것으로 추정하고 있다. 최근 동종유래 세포치료제 생산업체들의 관리 감독이 부실 의혹이 불거졌기 때문이다.
동종유래 세포치료제란 특정한 사람으로부터 적출된 세포나 조직을 다른 사람에게 제공할 수 있도록 공정 처리된 세포치료제다. 본인에게서 적출한 세포나 조직을 사용하는 자가유래 세포치료제와 달리 대량 생산이 가능하다는 이점이 있다.
동종유래 세포치료제는 허가 후 기존에 사용한 사람의 세포가 아닌 다른 사람에게 채취한 세포로 변경·추가됐을 경우 식약서에 품목변경 허가를 신청하고 안전성·유효성 재검사를 받아야 한다.
하지만 일부 동종유래 세포치료제를 생산하는 업체들이 식약처에 보고 없이 자체적으로 다른 사람에게 채취한 세포를 변경하거나 추가하고 있다는 의혹이 제기되면서 논란이 일고 있다.
식약처 실사가 있었던 지난 15일 4개사의 주가는 일제히 하락했다. 코오롱생명과학 6만9900원(-3.19%), 메디포스트 8만6800원(-2.36%), 테고사이언스 4만3700원(-4.17%), 바이오솔루션 3만6900원(-0.81%) 등으로 주가가 떨어졌다.
업계 관계자는 "이번 식약처 실사가 주가에 미친 영향이 없다고 볼 수는 없다"면서도 "네이처셀 사태 등의 악재를 비롯해 최근 전반적인 바이오주 급락이 심한 편이었다"고 언급했다.
식약처 실사를 받은 업체들은 관리 체계에 문제가 없다며 즉각 해명하고 나섰다.
코오롱생명과학은 "'인보사케이주'는 추가적인 세포 공여가 없었으며, 국제적으로 공인된 절차에 따라 동종세포를 관리하고 있다"며 "필요할 경우 모든 검증 절차를 받을 준비가 돼 있다"고 설명했다.
테고사이언스는 "자사 동종유래 세포치료제인 '칼로덤'의 마스터세포은행(MCB)는 최초 구축 이후 13년간 단 한번도 변경된 바 없다"며 "향후에도 변경되지 않을 것"이라고 강조했다.메디포스트 역시 "자사의 '카티스템' 제조 공정의 어떤 단계도 논란이 된 세포주와 관련이 없다"고 선을 그었다.
4개사뿐 아니라 동종유래 세포치료제를 생산하는 업체들은 이번 식약처 실사 결과에 촉각을 곤두세우고 있다. 실사 결과에 따라 업계 전반에 부정적인 영향을 미치는 것은 물론, 제품 신뢰도 문제와 직결될 수 있어 업체들의 기업가치가 하락할 수 밖에 없기 때문이다.
업계 관계자는 "이번 식약처 실사 결과에 따라 동종유래 세포치료제를 개발하는 기업들이 치명적인 타격을 받을 수 있다"고 우려했다.
한편, 식약처의 이번 실사 결과를 발표할 날은 아직 확정되지 않은 것으로 전해졌다.
동종유래 세포치료제 관리 부실 의혹
세포치료제 업계, 식약처 긴급 실사에 '비상'… 재평가 시발점 되나
- 김새미 기자
입력 2018-10-18 16:17수정 2018-10-18 16:57
공유하기
기사 공유하기
코오롱생명과학·테고사이언스·메디포스트·바이오솔루션 등 적극 해명식약처 실사 이유 함구… 업체들, 식약처 실사 결과에 '촉각'
김새미 기자







